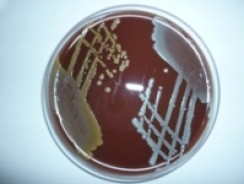
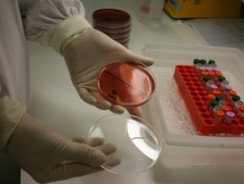

Each year, millions of people die from infectious diseases and malnutrition.
We are examining and developing solutions to threats posed by bacteria, parasites, viruses and fungi.
Through collaborative research and capacity building, we aim to find meaningful and relevant ways to improve the health of people in Australia and around the world.
-

-

-

-

-
-
Women and children's nutrition
The 1000 days between conception and two years of age is a critical window of action, when good nutrition can have a profound effect.